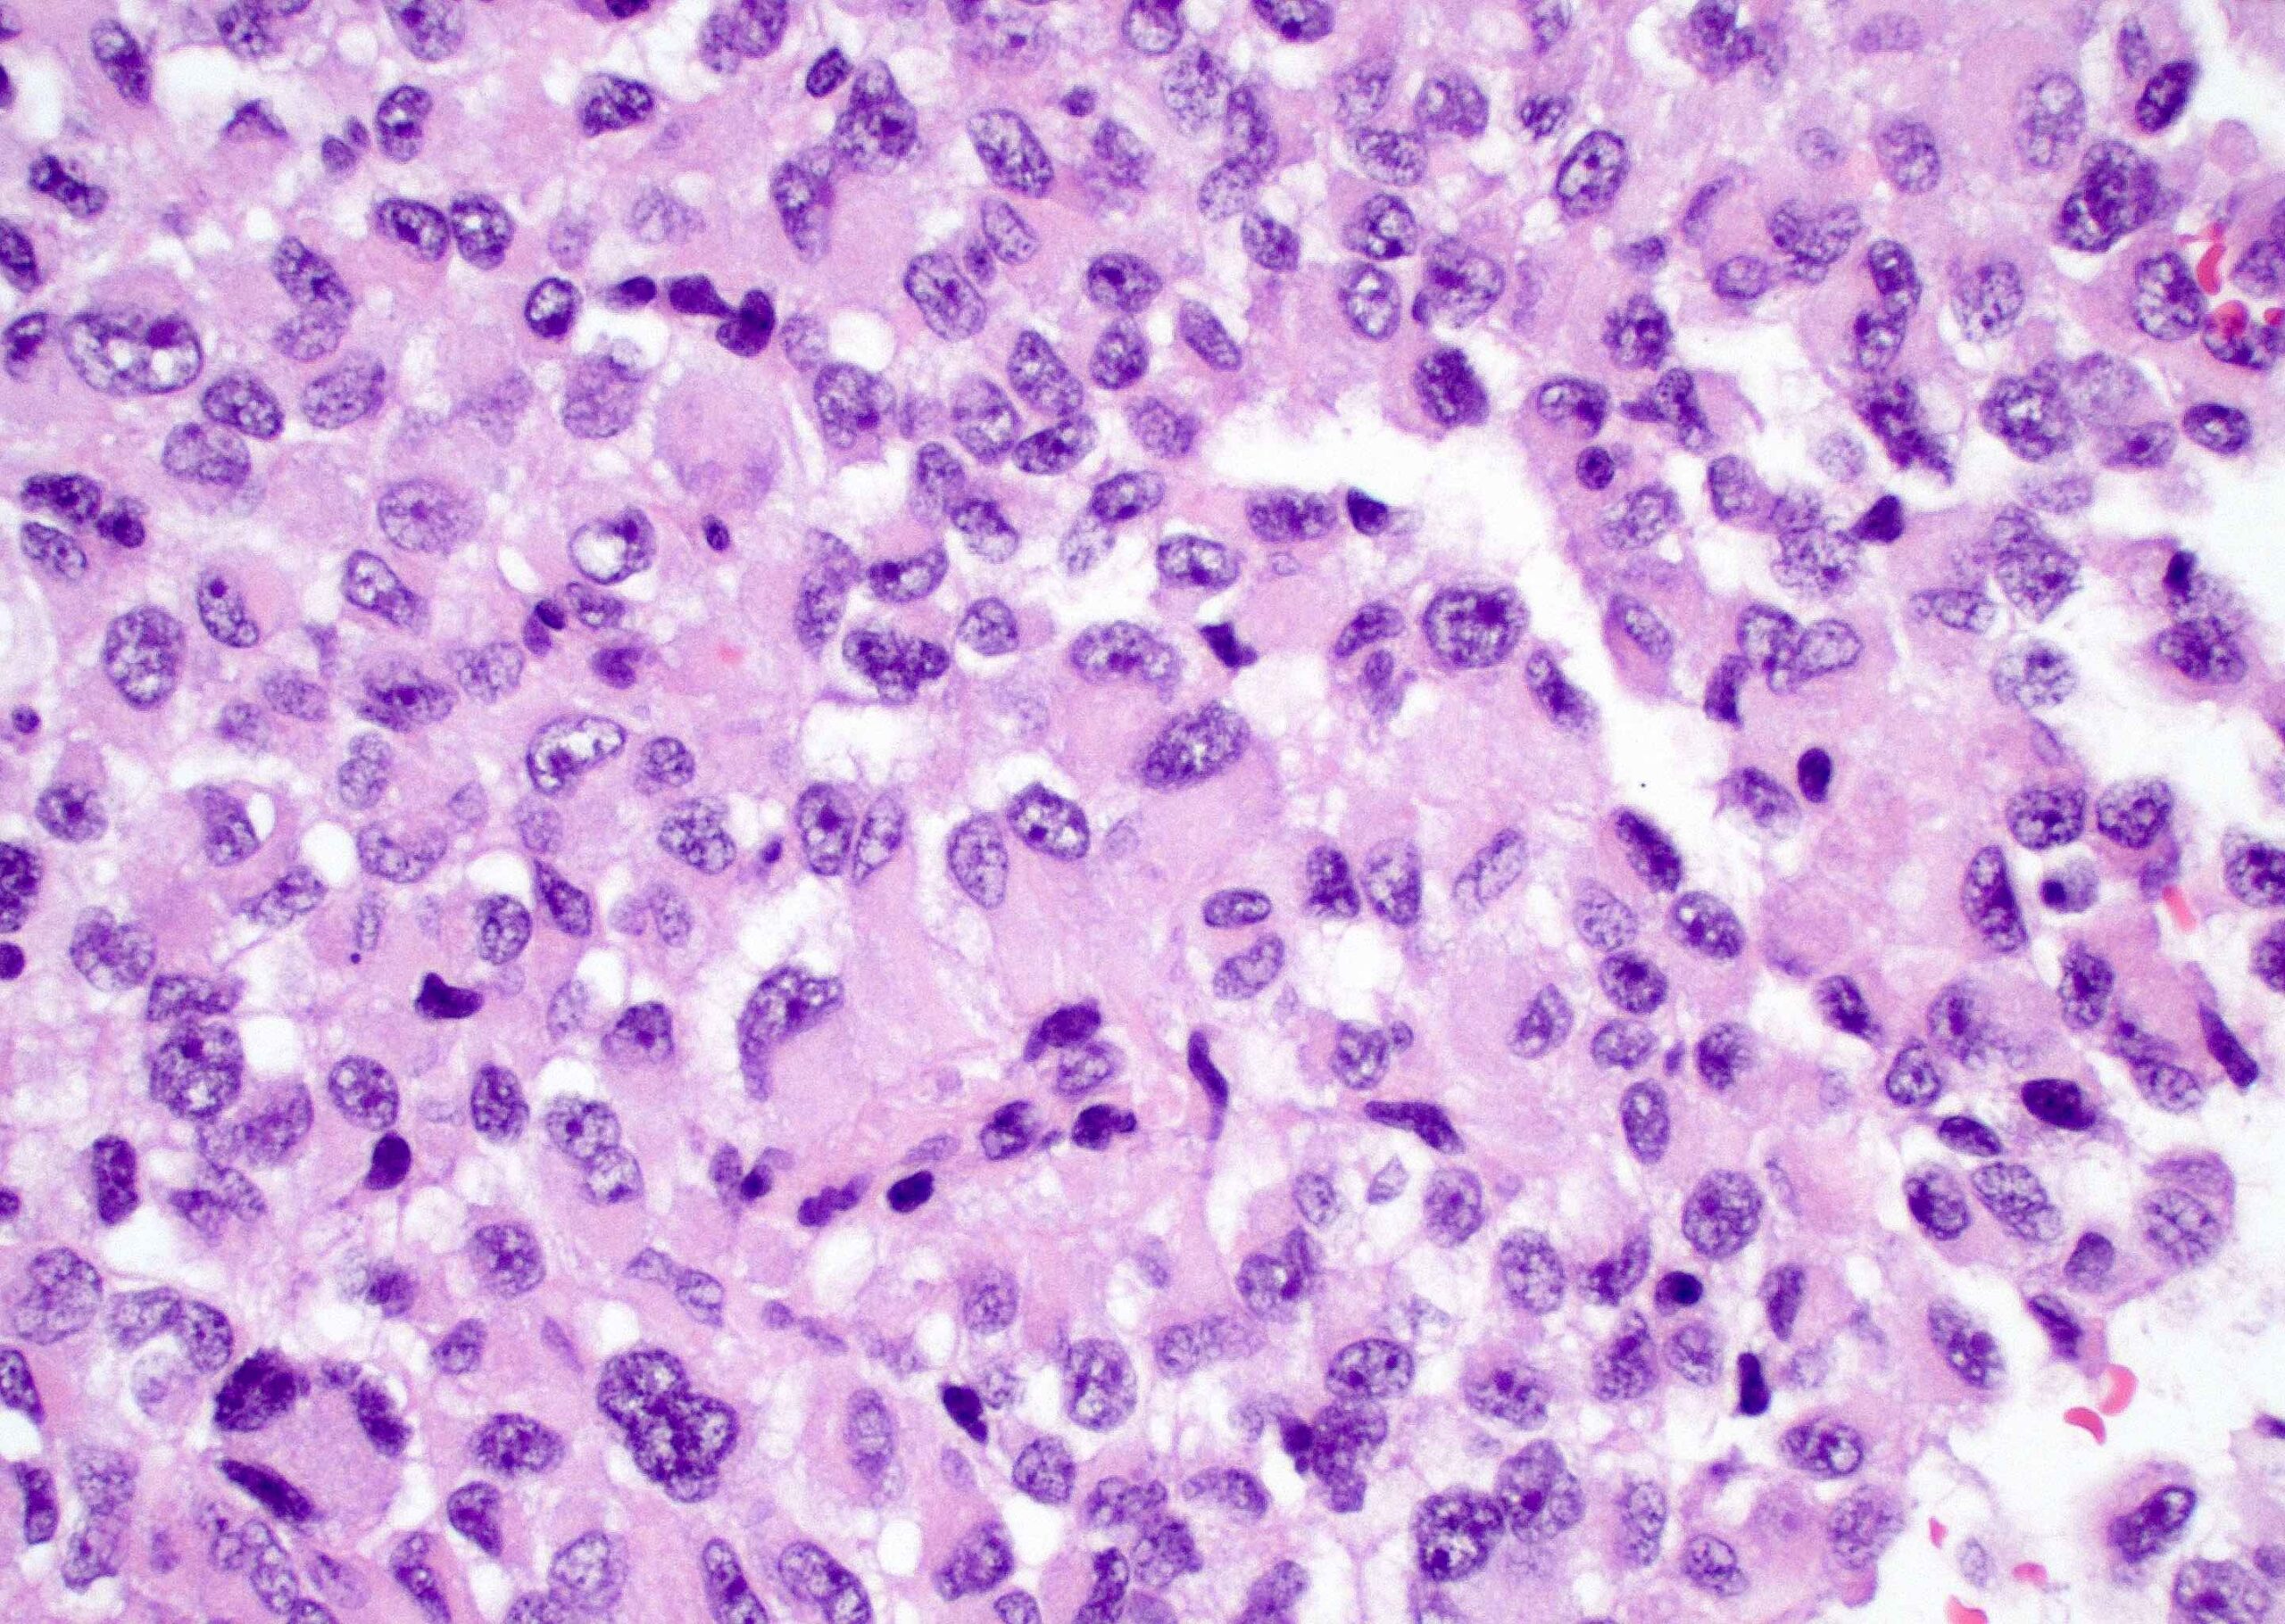
Diakonos Completes Phase 1 GBM Recruitment

Diakonos announced today it has completed enrollment for its Phase 1 trial of DOC1021, a unique dendritic cell vaccine, for Glioblastoma Multiforme (GBM). With the first patient enrolled in October 2021, DOC1021 has been administered to 16 patients across four dose levels.
To date, DOC1021 appears to be very safe and well tolerated as there have been no attributable serious adverse events observed from DOC1021. Additionally, 15 out of 18 patients remain alive today with the vast majority of patients still progression free.
“Completing the Phase 1 trial with both strong safety and efficacy signals was a critical step towards providing DOC1021 to all GBM patients,” said Mike Wicks, Chief Executive Officer of Diakonos, “Our focus now shifts towards manufacturing optimization underway with Cellipont Bioservices and enrolling additional sites for the upcoming Phase 2 trial.”